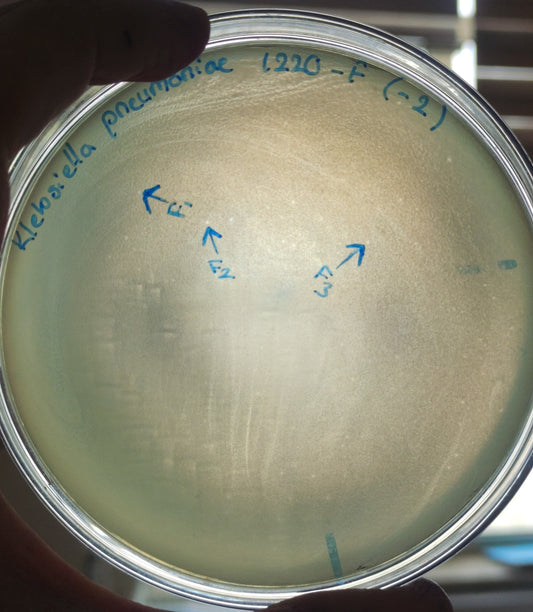
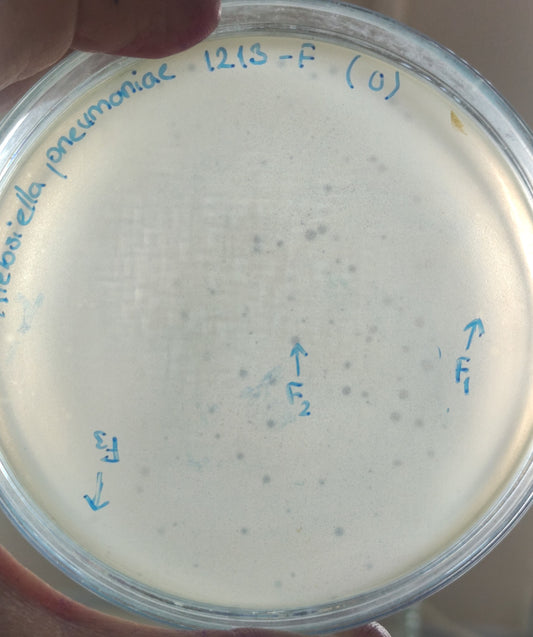
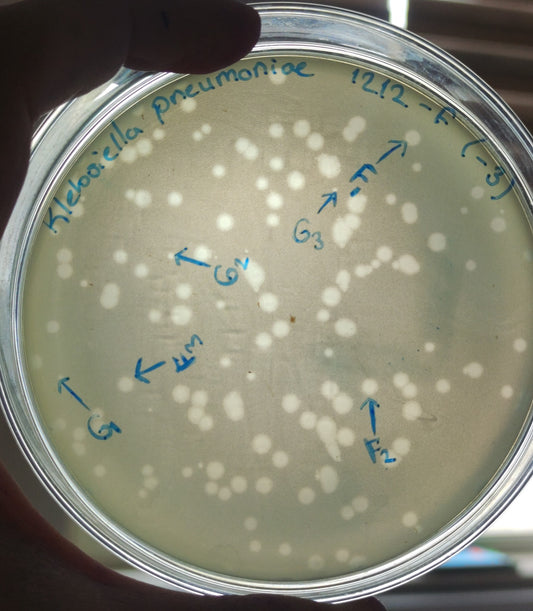
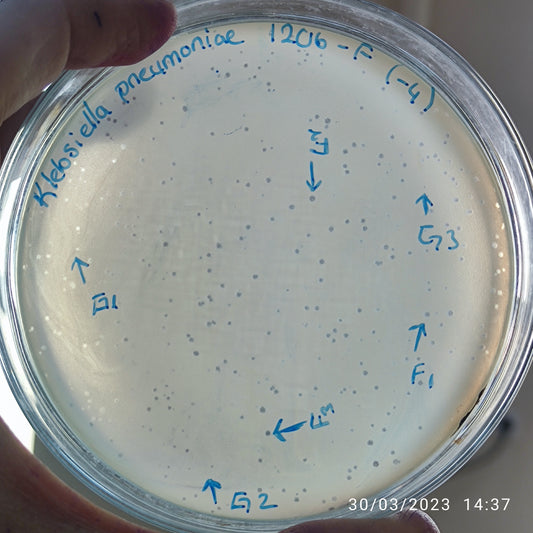
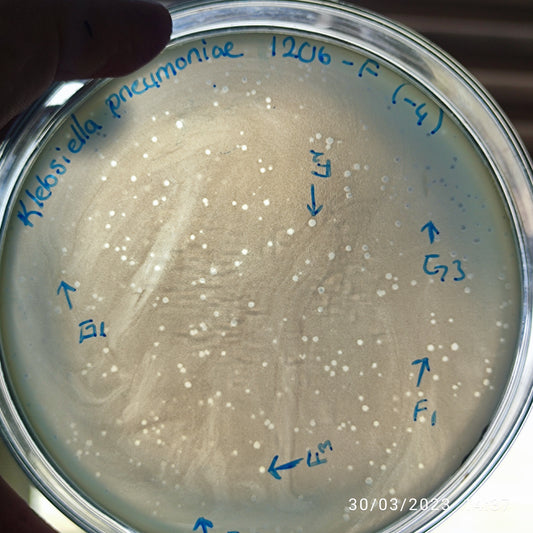

-
Klebsiella pneumoniae bacteriophage 180718F
Regular price $900.00 USDRegular priceUnit price per -
Klebsiella pneumoniae bacteriophage 180717F
Regular price $300.00 USDRegular priceUnit price per -
Klebsiella pneumoniae bacteriophage 180715F
Regular price $900.00 USDRegular priceUnit price per -
Klebsiella pneumoniae bacteriophage 180714F
Regular price $1,000.00 USDRegular priceUnit price per -
Klebsiella pneumoniae bacteriophage 180712F
Regular price $800.00 USDRegular priceUnit price per -
Klebsiella pneumoniae bacteriophage 180710F
Regular price $900.00 USDRegular priceUnit price per -
Klebsiella pneumoniae bacteriophage 180705F
Regular price $900.00 USDRegular priceUnit price per -
Klebsiella pneumoniae bacteriophage 180704F
Regular price $600.00 USDRegular priceUnit price per -
Klebsiella pneumoniae bacteriophage 180701F
Regular price $600.00 USDRegular priceUnit price per -
Klebsiella pneumoniae bacteriophage 181221F
Regular price $600.00 USDRegular priceUnit price per -
Klebsiella pneumoniae bacteriophage 181220F
Regular price $600.00 USDRegular priceUnit price per -
Klebsiella pneumoniae bacteriophage 181213F
Regular price $600.00 USDRegular priceUnit price per -
Klebsiella pneumoniae bacteriophage 181212G
Regular price $600.00 USDRegular priceUnit price per -
Klebsiella pneumoniae bacteriophage 181212F
Regular price $600.00 USDRegular priceUnit price per -
Klebsiella pneumoniae bacteriophage 181206G
Regular price $600.00 USDRegular priceUnit price per -
Klebsiella pneumoniae bacteriophage 181206F
Regular price $600.00 USDRegular priceUnit price per